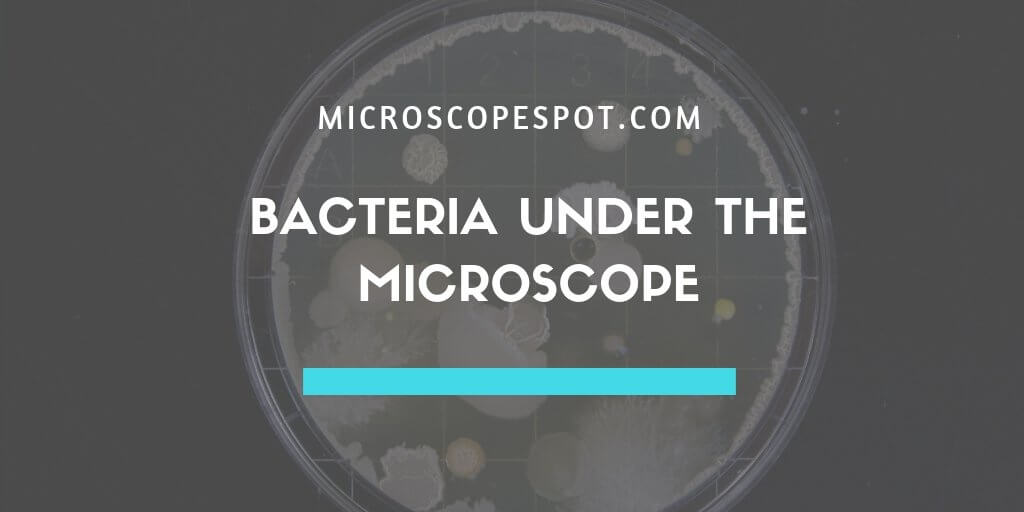
Bacteria Under the Microscope - MicroscopeSpot Bacteria Under the Microscope

Contents
ToggleWhat Are Bacteria?
Bacteria are single-celled organisms that are defined as prokaryotes, these are organisms that have cells with no defined nucleus or other specialized organelles.
In total, there are estimated to be millions of species of bacteria, which are diverse in shape, size and many other defining features. By visually inspecting bacteria for these physical characteristics, bacteria can be identified with the help of a light microscope.
Microscope Bacteria Preparation
Culturing Bacteria Species
Before certain bacteria can be seen under a light microscope, they first must be grown in a nutrient-rich culture media. Since bacteria have different nutrient requirements, the exact type of media used depends on the bacteria that is being selected for.
These are some common types of culture media used in modern microbiology laboratories:
- Nutrient Agar media – This is the most common type of nutrient media used and is a non-selective media that allows the growth of a wide variety of different species. This includes aerobic, anaerobic and microaerophilic microorganisms.
- Selective Agar -This a type of agar that inhibits the growth of certain bacteria while allowing the growth of another e.g. Mannitol salt agar is selective for Gram-positive bacteria.
- Differential Culture Media – This is a kind of media that is used to differentiate between bacteria. For example, blood agar is commonly used to identify bacteria that are responsible for hemolysis of the blood e.g. Streptococci.
Slide Preparation
Once the bacteria has been left to incubate and grow on the agar plate, it then is viewed under the microscope. In order to do this, a bacterial smear must be performed. This involves placing a thin layer of bacteria onto a glass slide, typically before staining it.
Materials Required:
- Bacteria sample
- Distilled water
- Light microscope
- Bunsen burner
- Inoculating loop
- Glass Slide
- Felt marker
The Procedure:
- Using your felt marker, place a small mark where you will be placing the bacteria and making the smear.
- Using an inoculating loop, place a small drop of water whee you are going to place the bacteria and perform the smear.
- The smear is now ready to be prepared. Firstly, place the inoculation loop into the blue portion of the flame of the bunsen burner. Allow the loop to glow red and then cool.
- Next, immediately remove a bacteria colony from the agar plate or broth using the loop. Remember to maintain good aseptic technique to prevent contamination of the sample.
- Mix the bacteria on the loop with the water you placed on the glass slide earlier and then flame your loop once again.
- Finally, allow the slide to air dry.
Staining Procedure Enhances Detail of Bacteria
When looking at bacteria under the microscope much of the bacteria can appear transparent without staining. Staining allows different structural components of the cells to be visualized including the cytoplasm, cell wall, and membranes. Common stains used on bacteria include crystal violet, methylene blue, and safranin.
The Procedure:
- Place your prepared slides next to each other on a paper towel or staining rack.
- Cover the slides in the chosen stain and leave for 1-2 minutes.
- Remove excess stain by running a gentle stream of water over the surface of the glass slide.
- Place the glass slide on the microscope stage and begin viewing the specimen. Begin with a low magnification and gradually increase to observe greater detail.
Microscope Bacteria Identification
Upon viewing the bacteria under the microscope, you will be able to identify the bacteria based on a wide variety of physical characteristics. This mainly involves looking at their shape and size.
Three Main Types of Bacteria Shapes
There are a wide variety of different shapes, yet the three main types are cocci, bacilli, and spiral.
Cocci – These are the most common type of bacteria. They are named cocci due to their spherical shape, although they commonly appear in groups. For instance, diplococci refer to pairs of cocci, streptococci refer to chains and staphylococci refers to clusters of cocci.
Bacilli – These are rod-shaped bacteria and just like cocci they can be found on their own or grouped. For example, diplobacilli refer to two bacilli next to each other, while streptobacilli refers to chains of bacilli.
Spiral – These are simply spiral-shaped bacteria. Examples include spirillium, which are thick, durable spirals and spirochetes, which are slender and flexible.
Are the Bacteria Gram Positive or Gram Negative?
Another useful way of identifying a bacteria is by determining whether it is a gram negative or gram positive. This is achieved through the staining process and stains such as crystal violet dye, iodine, and the counterstain safranin.
Gram Postive Bacteria – These are bacteria that have a thick peptidoglycan layer which the stain (crystal violet-iodine complex) is attracted to. As a result, the stain is retained resulting in them having a purple/bluish appearance when viewed down the microscope. Examples of gram-positive bacteria include Listeria, Streptococcus, and Bacillus.
Gram-Negative Bacteria – These are bacteria that do not have a thick layer of peptidoglycan and so the crystal violet-iodine complex is unable to be trapped within the structure. Instead, the bacteria can hold the safranin, which results in them having a red appearance under the microscope. Examples of gram-negative bacteria include proteobacteria and cyanobacteria.
The gram staining technique is an extremely useful technique, that will help identify a bacteria at the basic level, but not a species level.
Examples of Bacteria Under the Microscope
Escherichia coli:
Escherichia coli (E.coli) is a common gram-negative bacterial species that is often one of the first ones to be observed by students. Most strains of E.coli are harmless to humans, but some are pathogens and are responsible for gastrointestinal infections. They are a bacillus shaped bacteria that has a very fast growth (they can double every 20 minutes), which is one of the main reasons they are used in research.
Staphylococcus Aureus:
Staphylococcus Aureus (S. Aureus) is another round-shaped bacteria that is extremely common. It is abundant on the skin, in the nose and the respiratory tract. Just like E.coli, there are pathogenic strains of S. Aureus that are responsible for skin infections, abscesses, and respiratory infections.
This bacteria is ideal for the gram staining technique since it is a gram-positive bacteria, this means it has a thick peptidoglycan layer that will trap crystal violet and so will appear bluish/purple under the microscope.
What Type of Microscope is Best for Bacteria Observation?
Since bacteria are incredibly small and transparent, they can be extremely difficult to observe under a standard bright-field compound microscope. Instead, it’s common for researchers and scientists to use a phase contrast microscope instead.
A phase contrast microscope uses an optical technique that works by the use of a device to read the difference in thickness of the subject affecting the phasing of light resulting in a high contrast image. Staining bacteria also help microscope users to see bacterial structures that would have otherwise been invisible to the naked eye.